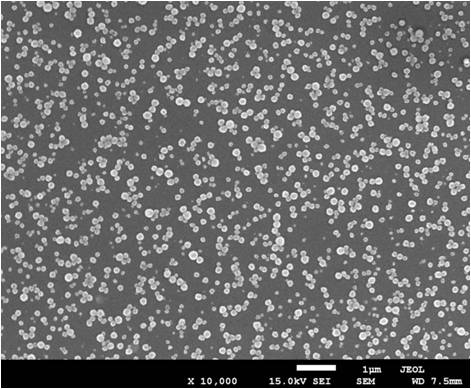

Wielowarstwowe cienkie filmy jako powłoki o właściwościach przeciwdrobnoustrojowych
Nanotechnologia – Innowacja dla świata przyszłości
Nanotechnologia jest nowym podejściem badawczym, które odnosi się do zrozumienia i doskonalenia właściwości materii w skali nano: jeden nanometr (jedna miliardowa metra) to długość małej cząsteczki. W takim wymiarze materia wykazuje zupełnie inne, częstokroć zaskakujące właściwości, w wyniku czego tradycyjnie wyznaczone granice pomiędzy dyscyplinami naukowymi i technicznymi ulegają zatarciu. Dlatego działania w zakresie nanotechnologii mają charakter wyraźnie interdyscyplinarny. Często twierdzi się, że nanotechnologia posiada potencjał „destruktywny” bądź „rewolucyjny” w sensie możliwości wpływu na przemysłowe techniki produkcji. Nanotechnologia oferuje potencjalne rozwiązania wielu bieżących problemów poprzez wykorzystanie mniejszych, lżejszych, szybszych i bardziej wydajnych materiałów, podzespołów i systemów, co prowadzi do powstawania nowych szans tworzenia dobrobytu i nowych miejsc pracy. Oczekuje się również, że nanotechnologia wniesie istotny wkład w proces rozwiązywania problemów globalnych i zmagania się z wyzwaniami ekologicznymi poprzez opracowywanie produktów i realizację procesów o bardziej konkretnych zastosowaniach, przyczyni się do oszczędzania zasobów i zmniejszenia emisji zanieczyszczeń. Obecnie na całym świecie rozwój nanotechnologii nabiera znacznego tempa. Stosunkowo wcześnie, bo już w drugiej połowie lat dziewięćdziesiątych dwudziestego wieku, środowiska europejskie zaczęły inwestować w liczne programy w zakresie nanonauki. Z czasem opracowano solidne podstawy naukowe, a obecnie niezbędne jest zapewnienie przemysłowi i społeczności europejskiej możliwości czerpania korzyści wypływających z tej wiedzy poprzez opracowywanie nowych produktów i procesów.
Obecnie nanotechnologia należy do najbardziej dynamicznie rozwijających się dziedzin w krajach wysoko uprzemysłowionych i znajduje coraz szersze zastosowanie m.in. w przemyśle elektronicznym, obronnym, chemicznym, żywnościowym czy kosmetycznym. Nanocząsteczki tlenku tytanu, srebra, tlenku cynku, platyny czy złota znajdują praktyczne zastosowanie w przemyśle kosmetycznym (ochronne kremy do opalania) i chemicznym (nowe rodzaje powłok antykorozyjnych, plamoodpornych tkanin, mydeł antyseptycznych). Rosnące koszty opieki zdrowotnej oraz zapotrzebowanie na mniej inwazyjne i skuteczniejsze procedury diagnostyki i terapii, zwróciły uwagę na ogromne możliwości nanotechnologii w obszarze medycyny. Według US National Science Foundation, opublikowanych w Med Tech Market Reports 2008, światowy rynek produktów i usług związanych z nanotechnologią osiągnie w 2015 roku wartość tryliona $. Unikalne właściwości fizykochemiczne nanocząsteczek znajdują praktyczne zastosowanie w wielu dyscyplinach medycyny. Rozdrobnienie w skali nano substancji leczniczych ułatwia ich przenikanie przez bariery biologiczne oraz zmienia ich aktywność farmakodynamiczną. Do nanomateriałów należą m.in. fullereny, nanorurki węglowe i rozgałęzione dendrymery. Do ich wnętrza mogą być wprowadzane antyseptyki, antybiotyki, chemioterapeutyki oraz inne leki, a związane zewnętrznie z nimi specyficzne przeciwciała powinny zapewnić transport nanocząsteczek do zawierających odpowiednie antygeny miejsc docelowych działania leków. Uzasadnione wydają się zatem oczekiwania, iż nanofarmakologia usprawni przenikanie leków przez bariery biologiczne i stworzy możliwość precyzyjnego transportu leku do chorej tkanki. Oznaczałoby to wzrost efektywności i obniżenie toksyczności leku. Ponadto, nanopreparaty umożliwiają równoczesne monitorowanie zmian patologicznych (diagnozowanie) oraz prowadzenie ściśle kontrolowanej pod kątem stężenia leku i miejsca działania. Jednym z wielu obecnie badanych zastosowań nowych nanomateriałów z użyciem np. nanocząstek metalicznych, jest ich wykorzystanie jako środków przeciwdrobnoustrojowych, które mogą posłużyć jako powłoki ochronne w celu zredukowania liczby infekcji np. w szpitalach czy jako powłoki w różnych materiałach medycznych ograniczając rozwój drobnoustrojów.
Świat pełen antybiotyków
Naukowcy alarmują: wokół nas coraz więcej antybiotyków! Ich powszechne stosowanie przynosi niekiedy więcej szkody niż pożytku. Bakterie stają się na nie mniej wrażliwe, ludzie uodparniają się na leki. Lekarzom coraz trudniej walczyć z chorobami. Dlatego, czy wkrótce będziemy bezradni wobec drobnoustrojów? Stosowanie antybiotyków to bardzo złożony problem. Antybiotyki istnieją w środowisku od wielu tysięcy lat, są bowiem w większości naturalnym produktem drobnoustrojów uwalnianym w niewielkich dawkach do środowiska. Jednak produkcja antybiotyków na skalę przemysłową spowodowała lawinowy wzrost ich obecności w najrozmaitszych dziedzinach życia. Najszybszy rozwój farmakologii i wzrost ilości stosowanych antybiotyków przypada na lata powojenne. Alarmujące raporty naukowców zwracają uwagę na rozmaite konsekwencje tego zjawiska. W szczególności w ciągu ostatnich 15 lat obserwuje się szybki i niekontrolowany rozwój oporności drobnoustrojów chorobotwórczych na stosowane w lecznictwie antybiotyki. Nie wszyscy „użytkownicy” antybiotyków zdają sobie sprawę ze złożoności procesów środowiskowych związanych z ich stosowaniem. Często, mimo że nie przyjmujemy tych leków bezpośrednio, jesteśmy pośrednio narażeni na skutki ich stosowania. Polacy znajdują się na 5 miejscu pod względem spożycia antybiotyków w Europie, a konsumpcja leków z tej grupy stale rośnie.
Nadużywanie i nieracjonalne stosowanie antybiotyków grozi pojawieniem się w bakteriach mutacji, które prowadzą do rozwoju ich oporności na antybiotyki. To między innymi dlatego polscy lekarze coraz częściej znajdują się w sytuacji, w której nie mają czym leczyć pacjentów z ciężkimi zakażeniami.

Rys. 1. Antybiotyk – koniec cudownego leku?
Wzrost oporności na antybiotyki grozi erą przedantybiotykową, gdy ludzie będą umierali na zwykłe zapalenie płuc, bo nie będzie ich czym leczyć, a organizm pozbawiony naturalnej odporności nie będzie mógł się bronić. Z powodu lekoopornych bakterii w Polsce umiera rocznie około 20-30 tysięcy osób.
Zgodnie z szacunkami Światowej Organizacji Zdrowia (WHO), co roku z powodu chorób zakaźnych umiera na świecie ponad 15 mln ludzi, a w niektórych krajach oporność bakterii na antybiotyki przybrała rozmiary epidemii. Lekarze w szpitalach i przychodniach na całym świecie stopniowo przegrywają bitwę z infekcjami wywołanymi przez bakterie oporne na działanie antybiotyków – z chorobami takimi jak gronkowcowe zakażenie gardła, zapalenie płuc, paciorkowcowe zakażenie gardła, gruźlica i inne, których leczenie jest coraz droższe i coraz trudniejsze – o ile w ogóle możliwe. Przez całe dziesięciolecia karmiono ludzi opowieściami o cudach, jakie zdziałały antybiotyki. Dopiero ostatnio lekarze zaczęli więcej uwagi poświęcać kwestii problemów związanych ze stosowaniem antybiotyków w leczeniu infekcji.
Należy oddać antybiotykom sprawiedliwość – uratowały niezliczone istnienia ludzkie, które bez ich pomocy poddałyby się naporowi infekcji. Już jednak sam odkrywca penicyliny, Aleksander Fleming, ostrzegł przed nadużyciem tego cudownego leku, wiodącym do powstania opornych na jego działanie bakterii. Jego słowa nie wzbudziły echa.
Zdaniem Waltera Gilberta, profesora Harvardu i laureata nagrody Nobla: zbliża się czas, gdy 80-90% wszystkich infekcji będzie opornych na leczenie znanymi nam antybiotykami.
Cóż za przerażająca myśl!
Ze stosowaniem antybiotyków wiążą się wzajemnie sprzeczne wyniki. Antybiotyki mają służyć choremu ciału jako wsparcie w zwalczaniu infekcji, lecz ich stosowanie może doprowadzić do pojawienia się nowych dolegliwości lub uporczywych nawrotów dawnych chorób, co w rezultacie zwiększa stopień zależności od antybiotyków. Lek ten zabija bakterie, lecz jednocześnie sprzyja powstawaniu nowych rodzajów bakterii opornych na jego działanie. To właśnie jest przyczyną, dla której antybiotyki, które niegdyś z łatwością pokonywały daną chorobę, są wobec niej obecnie bezradne. Antybiotyki stosuje się również w charakterze przejściowej osłony organizmu (zanim układ immunologiczny nie podejmie prawidłowego funkcjonowania), lecz w rzeczywistości ich działanie powoduje osłabienie reakcji odpornościowych organizmu. Co więcej, antybiotyki często bywają niewłaściwe dla danego typu infekcji, a mimo to lekarzy zniechęca się do stosowania leków zastępczych i innych form leczenia.
Paradoks największy ze wszystkich polega chyba na tym, iż upór z jakim współczesna medycyna polega na antybiotykach i syntetyzuje coraz nowe ich rodzaje, całkowicie przesłonił inne możliwości opanowania infekcji.
Poszukiwanie nowych cudownych leków pochłania miliony dolarów, które mogłyby sfinansować badania prowadzone pod kątem opracowania metod stymulacji funkcji immunologicznych organizmu czy też w celu odnalezienia przyczyn, dla których jedni pozostają zdrowi, podczas gdy inni zapadają na infekcje.
Bakterie lubią być w szpitalu
Nie ulega wątpliwości, że masowe stosowanie antybiotyków oprócz oczywistych pozytywnych skutków leczniczych powoduje powstawanie bakterii opornych na działanie antybiotyków, najczęściej w środowiskach szpitalnych. Związek ten jest szczególnie widoczny podczas epidemii zakażeń szpitalnych, czyli infekcji u pacjentów przebywających przez długi czas w szpitalu, najczęściej mających rozmaite zaburzenia układu odporności. Zbliżamy się do paradoksalnego momentu, w którym powszechne stosowanie antybiotyków przynosi coraz więcej szkód, a narastająca oporność drobnoustrojów powoduje niepokój naukowców i lekarzy, zagrażając wielu pacjentom. Szczególnie narażeni są tu najpoważniej chorzy. W wyniku kontaktów z osobami hospitalizowanymi dochodzi również do rozprzestrzeniania się oporności drobnoustrojów poza szpitale. Dlatego rozwój nowych, efektywnych oraz tanich środków przeciwbakteryjnych przy udziale nanotechnologii jest celem działalności badawczej wielu grup ze względu na budowanie odporności organizmu drobnoustrojów do tradycyjnych antybiotyków Jednym z potencjalnych zastosowań jest wykorzystanie nanocząstek metalicznych głównie srebra oraz miedzi, które są wysoce toksyczne dla mikroorganizmów, a niskotoksyczne dla człowieka. Charakteryzują się one wieloma cennymi właściwościami, m.in. działaniem przeciwbakteryjnym czy przeciwgrzybicznym (ogromna powierzchnia kontaktu z bakterią, grzybami) dlatego różnego rodzaju materiały oraz powłoki zawierające ww. nanocząstki mogą zostać wykorzystane np. w medycynie do powstrzymania rozwoju infekcji w szpitalach, w leczeniu oparzeń lub ochrony przed bakteriami i grzybami, które mogą się znajdować na protezach, cewnikach, materiałach dentystycznych. Poza tym ich produkcja jest szybka, tania oraz prosta.
Dlaczego nanocząstki?
Wspomniane nanocząstki srebra oraz miedzi wykazują silne działanie bakterio- i grzybobójcze oraz inne właściwości, niespotykane przy stosowaniu tradycyjnych koloidów. Określa się je jako niejonowe, co oznacza, że silnie zdyspergowana faza metaliczna takich koloidów nie zawiera chemicznie przyłączonych ujemnych grup anionowych, sam zaś metal nie występuje tutaj w postaci dodatniego kationu. W związku z ogromnymi wartościami powierzchni czynnych cząsteczki koloidu zbliżają się do siebie na odległość zaledwie kilku odległości cząsteczkowych, które dla przypadku wody wynoszą około 10 angstremów. Poza tym nanocząstki pozostają w stałym ruchu (tzw. ruchy Browna). W czasie tych ruchów, uzyskują niewielkie dodatnie ładunki elektryczne, co powoduje, że odpychają się wzajemnie, a także z dużą łatwością wnikają do wnętrza bakterii i komórek, które zawsze mają ładunki ujemne. Dlatego mówi się, że nanocząstki koloidalne są aktywne.
Nie są to jednak ładunki typu jonowego, a wobec tego nanocząstki metali nie wchodzą w reakcje chemiczne z innymi jonami znajdującymi się w przyrodzie i organizmach. Im mniejsza nanocząstka, tym lepsza będzie biobójcza skuteczność suspensji. Wirusy i bakterie są dużo większe od nanocząstek koloidalnych, które dzięki temu mogą swobodnie wnikać do wnętrza drobnoustrojów chorobotwórczych. Nanocząstki, szczególnie srebra, posiadają ogromną zdolność utleniania substancji, które je otaczają – nanokoloidalne srebro działa jak katalizator i upośledza enzym wykorzystywany przez drobnoustroje do przyswajania tlenu, powodując śmierć wszystkich mikroorganizmów jednokomórkowych. W efekcie mikroorganizmy te i ich formy wielopostaciowe, czy zmutowane, giną w kilka minut po bezpośrednim kontakcie ze srebrem nanokoloidalnym. Ponadto organizmy chorobotwórcze nie potrafią wypracować odporności na srebro (a tak się dzieje, w przypadku antybiotyków), a ich mutacje są tak samo podatne na jego błyskawiczne działanie. W żadnym z badań naukowych nie zanotowano powstawania szczepów bakterii odpornych na działanie nanokoloidów metalicznych. Nanocząstki wytwarzane są w wysokiej jakości wodzie pozbawionej substancji jonowych. Suspensje nanocząstek mogą być wykonywane w innych od wody ośrodkach takich jak wodne roztwory alkoholi, kwasów organicznych, estrów, eterów, w polimerach, rozpuszczalnikach organicznych. Można wytwarzać szeroki asortyment metalicznych nanokoloidów jednoskładnikowych, bądź też wieloskładnikowych. Przykładami takich nanokoloidów są: nanokoloidy platynowców, stopu złota, srebra i miedzi, stopów dentystycznych i podobnych. Nanocząstki metaliczne różnią się między sobą właściwościami, np. nanosrebro jest bardzo silnie bakteriobójcze i nieco słabiej działa grzybobójczo, z kolei nanocząstki miedzi mają najsilniejsze działanie grzybobójcze, ale nieco słabsze działanie bakteriobójcze.
Metodyka tworzenia filmów polimerowych
Ultracienkie wielowarstwowe filmy polimerowe to filmy o grubości kilku, kilkunastu nanometrów. Jak wiadomo 1 nm stanowi jedną miliardową część metra, wobec czego nie sposób dostrzec gołym okiem tak ultracienkie warstwy. Cienkie wielowarstwowe filmy polielektrolitowe są konstruowane przy użyciu techniki „warstwa po warstwie”(z ang. „layer by layer”), zaproponowanej przez Dechera oraz jego współpracowników, która cieszy się dużym zainteresowaniem oraz jest szeroko stosowana i wykorzystywana w ostatnich latach. Jest to metoda, która pozwala budować wielowarstwowe filmy niezależnie od natury, rozmiarów oraz topologii substratu. Jest wykorzystywana przede wszystkim w układach zawierających polimery, ale także np. nanocząstki. Metoda elektrostatycznej samoorganizacji tworzenia filmów polega na naprzemiennym nakładaniu na naładowaną powierzchnię substratu, substancji naładowanych przeciwnie do powierzchni. Sekwencyjna adsorpcja polimerów mających ładunek i/lub nanocząstek przedstawia wartościową technikę tworzenia cienkich multiwarstw (rys. 2).
Rys. 2. Schemat tworzenia filmu metodą „warstwa po warstwie”. (1) – ujemnie naładowane podłoże, (2) – roztwór polikationu, (3) – adsorpcja pierwszej warstwy tworzonego filmu, (4), (8) – roztwory do płukania, (5) – pierwsza trwale zaadsorbowana warstwa po płukaniu, (6) – ujemnie naładowana suspensja nanocząstek , (9) – druga trwale zaadsorbowana warstwa filmu po płukaniu.
Cienkie warstwy polimerowe stosuje się w celu modyfikacji właściwości powierzchni różnorodnych materiałów, m.in. zapewnienie biokompatybilności, przewodnictwa bądź izolacyjności. Wielowarstwowe filmy polimerowe wykazały wiele zastosowań m.in. jako powierzchnie „samoczyszczące się”, sensory, warstwy przewodzące, warstwy antykorozyjne, antybakteryjne czy też jako powłoki ochronne np. komórki, leki. Charakteryzują się wieloma zaletami oraz możliwościami, jak np. są proste i łatwe w otrzymaniu, po immobilizacji nie zmywają się, łatwe nanoszenie z roztworów wodnych, odporne na działanie wody oraz rozpuszczalników organicznych, a także niska cena ich wytwarzania. W poszczególnych warstwach można również umieścić różne związki z nm precyzją, np. białka, wirusy, cząstki np. złota, srebra, miedzi
Badania i analiza wyników
Głównym celem prezentowanej pracy było opracowanie syntezy suspensji nanocząstek srebra oraz miedzi jako środków wykazujących właściwości przeciwbakteryjne, a następnie przygotowanie ultracienkich wielowarstwowych filmów polielektrolitowych zawierających ww. nanocząstki jako powłok o właściwościach przeciwdrobnoustrojowych. W budowie multiwarstw polietylenoimina (PEI) została wykorzystana jako warstwa izolacyjna. Kolejne warstwy zostały zbudowane za pomocą chlorowodorku poliallyloaminy (PAH) pełniącego funkcję polikationu, ze względu na trwały ładunek dodatni oraz ujemnie naładowanych nanocząstek srebra (Ag) oraz miedzi (Cu) pełniących funkcję polianionu. Uzyskany w ten sposób cienki wielowarstwowy film został scharakteryzowany przy użyciu szeregu technik, takich jak: elipsometria spektroskopowa, skaningowa mikroskopia elektronowa (SEM), mikrowaga kwarcowa (QCM) oraz absorpcyjna spektrometria UV-Vis.
Nie sposób w krótkim artykule opisać wszystkie problemy oraz dyskusje wyników, związane z przedstawionym zagadnieniem, dlatego skupiono się na najważniejszym aspekcie pracy, mianowicie omówieniu otrzymanych warstw polielektrolitowych z nanocząstkami metalicznymi, mającymi służyć jako powłoki do różnych zastosowań biomedycznych. Poniżej przedstawiono przykładowe zdjęcia warstw polielektrolitowych z naocząstkami srebra oraz miedzi, uzyskane przy użyciu skaningowej mikroskopii elektronowej (SEM). Widać wyraźnie efektywne otrzymanie multiwarstw z wbudowanymi nanocząstkami srebra (rys. 3) oraz miedzi (rys. 4). przez zastosowanie techniki „warstwa po warstwie”. Porównując oba zdjęcia, można zauważyć że rozmiary nanocząstek srebra (4 nm) są zdecydowanie mniejsze w porównaniu z nanocząstkami miedzi (40 nm).

Rys.3. Film polielektrolitowy z nanocząstkami srebra Rys.4. Film polielektrolitowy z nanocząstkami miedzi
Nadrzędnym celem było wykazanie, że ultracienkie powłoki polimerowe z nanocząstkami wykazują przeciwdrobnoustrojowe działania i mogą posłużyć jako warstwy ochronne np. w protezach, cewnikach czy specjalistycznych materiałach dentystycznych, jak i również materiałach szpitalnych ograniczając rozwój bakterii. Poniżej zamieszczono przykładowy wynik badań aktywności mikrobiologicznej (dr Joanna Stefańska; Warszawski Uniwersytet Medyczny, Zakład Mikrobiologii Farmaceutycznej) otrzymanych filmów z wbudowanymi nanocząstkami srebra (rys. 5).

Rys. 5. Wyniki badań aktywności mikrobiologicznej filmów
Hodowano wzorcowy szczep gronkowca skórnego tworzący biofilm na płytce zawierającej nanocząstki srebra, równocześnie na płytce referencyjnej bez nanocząstek przez 20 godzin, następnie były barwione fluorescencyjnie. Świecące na zielono to żywe komórki bakteryjne, a czerwone punkty to komórki martwe (w zestawie 3 zdjęcia – same żywe, same martwe oraz nałożenie martwych na żywe). Patrząc na te zdjęcia widać wyraźnie różnicę w ilości biofilmu, zdecydowanie mniej jest na płytce pokrytej srebrem, co świadczy o tym, że nanocząstki srebra wykazują pożądane działanie przeciwbakteryjne.
Podsumowując, w przedstawionej pracy otrzymano stabilne suspensje nanocząstek srebra AgNP oraz miedzi CuNP o zbadanych własnościach przeciwdrobnoustrojowych.
Następnie otrzymane nanocząstki wbudowano w strukturę filmu polielektrolitowego omówioną wcześniej techniką „layer-by-layer”. Otrzymane filmy polielektrolitowe zawierające nanocząstki wykazują właściwości przeciwdrobnoustrojowe, co może być początkiem rozwoju nowych, efektywnych, tanich środków przeciwbakteryjnych oraz przeciwgrzybicznych przy udziale nanotechnologii, które mogą w przyszłości pozwolić na wytworzenie specjalistycznych powłok antyseptycznych. Wielowarstwowe filmy polimerowe zawierające nanocząstki wykazują wiele interesujących praktycznych zastosowań, nie tylko jako warstwy przeciwbakteryjne, przeciwgrzybiczne czy też powłoki ochronne, które mogą zostać wykorzystane w przyszłości w różnych obszarach nanomedycyny czy nanofarmakologii.
Literatura
[1] Bogunia-Kubik K. Sugisaka M.: From molecular biology to nanotechnology and nanomedicine. Biosystems, 2002.
[2] Jędrzejczyk W.: Nanotechnologia w medycynie. Meritum, 2006, (www.gazetalekarska.pl/xml/oil).
[3] Kaliszan R.: Nanotechnologia w medycynie i farmacji. Medycyna Praktyczna, 2007, Online (www.mp.pl/kurier/index.php).
[4] Kubik T, Bogunia-Kubik K, Sugisaka M.: Nanotechnology on duty in medical applications. Curr Pharm Biotechnol., 2005.
[5] Michael Schmidt: Ominąć antybiotyki. Spółdzielcza Agencja Reklamowa SPAR , 1999, Online (http://www.zdrowi.com.pl/antybiotyki.htm)
[6] M. D. Musick,., D. J. Pena, S. L. Botsko, Langmuir, 1999
[7] S. Hrapovic, Y. Liu, G. Enright, Langmuir, 2003
[8] K. R. Brown, L. A. Lyon, A. P. Fox, Chem. Mater., 2000
[9] M. K. Corbierre, N. S. Cameron, M. Sutton, S. G. J. Mochrie, L. B. Lurio, A. Rühm, R. B. Lennox, J. Am. Chem. Soc. 2001
[10] Multilayer Thin Films, edited by G. Decher, J.B. Schlenoff, 2003, Wiley – VCH
*mgr Tomasz Kruk; Instytut Katalizy i Fizykochemii Powierzchni PAN w Krakowie, e-mail: nckruk@cyf-kr.edu.pl(link sends e-mail)
